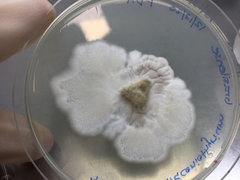
Paraconiothyrium brasiliense
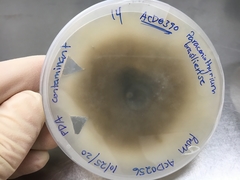
Paraconiothyrium brasiliense
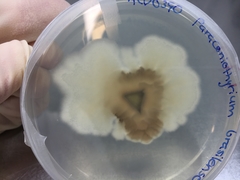
Paraconiothyrium brasiliense
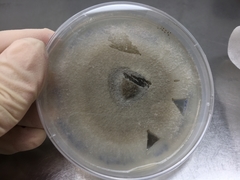
Paraconiothyrium brasiliense

Paraconiothyrium brasiliense: taxon details and analytics
- Domain
- Kingdom
- Fungi
- Phylum
- Ascomycota
- Class
- Dothideomycetes
- Order
- Pleosporales
- Family
- Didymosphaeriaceae
- Genus
- Paraconiothyrium
- Species
- Paraconiothyrium brasiliense
- Scientific Name
- Paraconiothyrium brasiliense